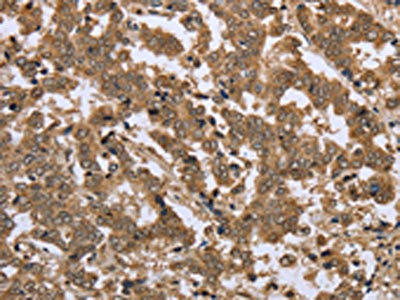

IKBKE Antibody
-
中文名稱:IKBKE兔多克隆抗體
-
貨號:CSB-PA987228
-
規格:¥1100
-
圖片:
-
The image on the left is immunohistochemistry of paraffin-embedded Human prostate cancer tissue using CSB-PA987228(IKBKE Antibody) at dilution 1/25, on the right is treated with fusion protein. (Original magnification: ×200)
-
The image on the left is immunohistochemistry of paraffin-embedded Human liver cancer tissue using CSB-PA987228(IKBKE Antibody) at dilution 1/25, on the right is treated with fusion protein. (Original magnification: ×200)
-
Gel: 6%SDS-PAGE, Lysate: 50 μg, Lane: Raji cells, Primary antibody: CSB-PA987228(IKBKE Antibody) at dilution 1/400, Secondary antibody: Goat anti rabbit IgG at 1/8000 dilution, Exposure time: 30 seconds
-
-
其他:
產品詳情
-
Uniprot No.:
-
基因名:
-
別名:I kappa B kinase epsilon antibody; I-kappa-B kinase epsilon antibody; IkBKE antibody; IKK related kinase epsilon antibody; IKK-E antibody; IKK-epsilon antibody; IKK-i antibody; IKKE antibody; IKKE_HUMAN antibody; IKKepsilon antibody; IKKI antibody; Inducible I kappa B kinase antibody; Inducible I kappa-B kinase antibody; Inducible IkappaB kinase antibody; Inhibitor of kappa light polypeptide gene enhancer in B cells kinase epsilon antibody; Inhibitor of kappa light polypeptide gene enhancer in B cells, kinase of, epsilon antibody; Inhibitor of nuclear factor kappa-B kinase subunit epsilon antibody; KIAA0151 antibody; MGC125294 antibody; MGC125295 antibody; MGC125297 antibody
-
宿主:Rabbit
-
反應種屬:Human,Mouse
-
免疫原:Fusion protein of Human IKBKE
-
免疫原種屬:Homo sapiens (Human)
-
標記方式:Non-conjugated
-
抗體亞型:IgG
-
純化方式:Antigen affinity purification
-
濃度:It differs from different batches. Please contact us to confirm it.
-
保存緩沖液:-20°C, pH7.4 PBS, 0.05% NaN3, 40% Glycerol
-
產品提供形式:Liquid
-
應用范圍:ELISA,WB,IHC
-
推薦稀釋比:
Application Recommended Dilution ELISA 1:1000-1:2000 WB 1:200-1:1000 IHC 1:50-1:200 -
Protocols:
-
儲存條件:Upon receipt, store at -20°C or -80°C. Avoid repeated freeze.
-
貨期:Basically, we can dispatch the products out in 1-3 working days after receiving your orders. Delivery time maybe differs from different purchasing way or location, please kindly consult your local distributors for specific delivery time.
-
用途:For Research Use Only. Not for use in diagnostic or therapeutic procedures.
相關產品
靶點詳情
-
功能:Serine/threonine kinase that plays an essential role in regulating inflammatory responses to viral infection, through the activation of the type I IFN, NF-kappa-B and STAT signaling. Also involved in TNFA and inflammatory cytokines, like Interleukin-1, signaling. Following activation of viral RNA sensors, such as RIG-I-like receptors, associates with DDX3X and phosphorylates interferon regulatory factors (IRFs), IRF3 and IRF7, as well as DDX3X. This activity allows subsequent homodimerization and nuclear translocation of the IRF3 leading to transcriptional activation of pro-inflammatory and antiviral genes including IFNB. In order to establish such an antiviral state, IKBKE forms several different complexes whose composition depends on the type of cell and cellular stimuli. Thus, several scaffolding molecules including IPS1/MAVS, TANK, AZI2/NAP1 or TBKBP1/SINTBAD can be recruited to the IKBKE-containing-complexes. Activated by polyubiquitination in response to TNFA and interleukin-1, regulates the NF-kappa-B signaling pathway through, at least, the phosphorylation of CYLD. Phosphorylates inhibitors of NF-kappa-B thus leading to the dissociation of the inhibitor/NF-kappa-B complex and ultimately the degradation of the inhibitor. In addition, is also required for the induction of a subset of ISGs which displays antiviral activity, may be through the phosphorylation of STAT1 at 'Ser-708'. Phosphorylation of STAT1 at 'Ser-708' seems also to promote the assembly and DNA binding of ISGF3 (STAT1:STAT2:IRF9) complexes compared to GAF (STAT1:STAT1) complexes, in this way regulating the balance between type I and type II IFN responses. Protects cells against DNA damage-induced cell death. Also plays an important role in energy balance regulation by sustaining a state of chronic, low-grade inflammation in obesity, wich leads to a negative impact on insulin sensitivity. Phosphorylates AKT1.
-
基因功能參考文獻:
- fascin1 constitutively interacts with IkappaB kinase (IKK) in the RIG-I signaling pathway. In summary, we have identified fascin1 as a suppressor of the RIG-I signaling pathway associating with IkappaB kinase in DLD-1 colon cancer cells to suppress immune responses to viral infection. PMID: 29496994
- Single-Nucleotide Polymorphism in IKBKE gene had a strong association with resistance or susceptibility to dengue disease. PMID: 30332343
- These findings indicated that microRNA-98 could promote apoptosis of glioma cells via inhibiting inhibitor of kappa B kinase epsilon/nuclear factor-kappa B signaling and presented a novel regulatory pathway of microRNA-98 by direct suppression of inhibitor of kappa B kinase epsilon/nuclear factor-kappa B expression in glioma cells. PMID: 29333957
- In conclusion, the spindle cell morphology should be induced by RelA activation (p-RelA S468) by IKKepsilon upregulation in human herpesvirus 8 vFLIP-expressing EA hy926 cells. PMID: 30029010
- Studied association between nuclear factor kappa beta1/IKK epsilon (NF-kappaB1/IKKepsilon) gene expression and clinical activity in rheumatoid arthritis (RA). Found there were significant differences in NF-kappaB1 and IKKepsilon gene expression (P PMID: 29069487
- IKBKE plays a pivotal role in regulating cell proliferation, invasion and epithelial-mesenchymal transition of malignant glioma cells in vitro and in vivo by impacting on the Hippo pathway. PMID: 28548934
- Inverse association between IKKepsilon and lymph node metastasis in breast cancer. PMID: 28532474
- YPEL5 silencing enhanced the induction of IFNB1 by pattern recognition receptors and phosphorylation of TBK1/IKBKE kinases, whereas co-immunoprecipitation experiments revealed that YPEL5 interacted physically with IKBKE. PMID: 27705791
- Virus-activated kinase IKKepsilon phosphorylated YAP at Ser403 and thereby triggered degradation of YAP in lysosomes and, consequently, relief of YAP-mediated inhibition of the cellular antiviral response. PMID: 28481329
- We then determined that YAP1 negatively regulates miR-let-7b/i by overexpressing and silencing YAP1 expression. In addition, miR-let-7b/i feedback decreases the expression of IKBKE and YAP1 and suppresses the transportation of YAP1 located in the nucleus. Therefore, the regulatory feedback circuit of IKBKE upward arrow-->YAP1 upward arrow-->miR-let-7b/i downward arrow-->IKBKE upward arrow dictates glioblastoma progress... PMID: 28677425
- our findings highlight the functional importance of IKBKE in pancreatic cancer PMID: 28069799
- we define a pathobiologic function for IKKepsilon in reprogramming glucose metabolism and driving progression in pancreatic ductal adenocarcinoma PMID: 27923829
- demonstrate a key role of TBK1/IKKepsilon in the survival and proliferation of HTLV-1-transformed T cells PMID: 27123832
- Data suggest that changes in inhibitor of nuclear factor kappa B kinase subunit epsilon (IKKepsilon) and TANK-binding kinase 1 (TBK1) expression may be involved in the development of intestinal-type gastric cancer. PMID: 27145266
- Live NiV infection, but not a recombinant NiV lacking the M protein, reduced the levels of endogenous TRIM6 protein expression. To our knowledge, matrix proteins of paramyxoviruses have never been reported to be involved in innate immune antagonism. We report here a novel mechanism of viral innate immune evasion by targeting TRIM6, IKKepsilon and unanchored polyubiquitin chains. PMID: 27622505
- These findings collectively support the conclusion that IKK modulates innate immune signaling cascades via phosphorylating the RIG-I cytosolic sensor, providing a feedback regulatory mechanism. PMID: 26354181
- Blunting of NOX2-dependent IKKepsilon oncogenic kinase expression reduces proliferation and viability of human breast cancer cells. PMID: 26177467
- The P proteins from the rabies virus street strains 1088 and HCM-9 significantly inhibited I-kappa B kinase (IKK)-inducible IRF-3-dependent IFN-beta promoter activity. PMID: 26647356
- IKBKE Upregulation is Positively Associated with Squamous Cell Carcinoma of the Lung In Vivo and Malignant Transformation of Human Bronchial Epithelial Cells In Vitro. PMID: 26025939
- DC-SIGN directs adaptive T helper cell type-2immunity to fucose-expressing pathogens via an IKKepsilon-CYLD-dependent signalling pathway leading to Bcl3 activation. PMID: 24867235
- these findings reveal that IKBKE-associated cytokine signaling promotes tumorigenicity of immune-driven TNBC and identify a potential therapeutic strategy using clinically available compounds. PMID: 25365225
- A role for APPL1 in TLR3/4-dependent TBK1 and IKKepsilon activation in macrophages. PMID: 25780039
- The results highlight the importance of the C-terminal region in the functional activity of IKKepsilon in innate immune response.Interestingly, corresponding region and residues are not required for activation of downstream signaling by TBK1. PMID: 24722368
- The above-mentioned data suggest that let-7b/i inhibit the invasive ability of glioma cells by directly downregulating IKBKE and indirectly upregulating E-cadherin. PMID: 25656572
- IKBKE is a novel regulator that limits chronic inflammation during metabolic disease and atherosclerosis. The pathogenic relevance of IKBKE was indicated by the colocalization with macrophages in tissues and in atherosclerotic plaques. PMID: 25540417
- HTLV-1 Tax is recruited into the TBK1/IKKvarepsilon complexes as a scaffolding-adaptor protein that enhances IFN-beta gene expression. PMID: 25531185
- Authors identified polymorphisms in the IkBepsilon gene associated with spontaneous hepatitis C resolution in two independent cohorts. PMID: 24224717
- in this work, we identified TPCA-1 as a direct dual inhibitor for both IKKs and STAT3, whereas treatment targeting EGFR only could not sufficiently repress NF-kappaB and STAT3 pathways for lung cancers harboring mutant EGFR. PMID: 24401319
- probe F2 facilitated the identification of the target spectrum of the two inhibitors confirming many of the previously identified (off-) targets such as AURKA, FLT4-VEGFR3, IKBKE and PDGFRbeta. PMID: 24184958
- Using interaction assays, authors found that dengue virus NS2B/3 interacts with the cellular IkappaB kinase epsilon (IKKepsilon). PMID: 24173023
- Through interaction with TBK1, phlebovirus nonstructural protein sequester the IKKepsilon and IRF3 into viral inclusion bodies. PMID: 24335286
- IKK-epsilon phosphorylated the transcription factor IFN regulatory factor 1 (IRF-1). PMID: 24396068
- study provides convinced morphologic evidence that VMAT2 is not present in beta cells PMID: 24155403
- we summarize the roles of IKKepsilon and TBK1 in different diseases and outline therapeutic options for modulation of these kinases PMID: 23157677
- IKKepsilon increases ERalpha-36 expression and is involved in ERalpha-36 mediated non-genomic estrogen signaling. PMID: 23816933
- Ten IKBKE SNVs were associated with systemic lupus erythematosus. PMID: 23535865
- IKBKE regulates FOXO3a primarily through phosphorylation of SerS644 PMID: 23691078
- Sp1 is required for IL-15 induction by both poly(I:C) and respiratory syncytial virus, a response that also requires NFkappaB2 and IKKepsilon. PMID: 23873932
- DDX3 is a scaffolding adaptor that directly facilitates phosphorylation of IRF3 by IKK-epsilon. PMID: 23478265
- IkappaBepsilon may be an effective target for HIV latency reactivation in T-cell and macrophage lineages. PMID: 23365428
- These experiments demonstrated direct physical interactions of the IKKepsilon and TBK1 kinases with hepatitis C virus NS2. PMID: 23096996
- IKBKE is a direct target of STAT3 and is induced by tobacco carcinogens through STAT3 pathway. PMID: 22330135
- This work defines TRAF2 phosphorylation to be one key effector of IKKE-induced mammary epithelial cell transformation. PMID: 23007157
- these data provide evidence that IKK-epsilon is a key coordinator of invasion and metastasis programs in ovarian cancer PMID: 22942254
- NP-IKKepsilon interaction likely plays a crucial role in arenavirus-host interaction. PMID: 22532683
- phosphorylation of IRF7 on Ser477 and Ser479 by IKKepsilon or TBK1 is inhibited by KSHV ORF45 PMID: 22787218
- deregulation of IKKepsilon plays a pivotal role in the uncontrolled proliferation and malignant invasion of glioma cells PMID: 22552702
- identify FOXO3 as a new IKK-epsilon-controlled check-point of IRF activation and regulation of IFN-beta expression, providing new insight into the role of FOXO3 in immune response control. PMID: 22531926
- IKBKE and gene expression patterns for other members of the NF-kappaB pathway were not associated with survival, suggesting that IKBKE gene expression may be an independent marker of variation in overall survival PMID: 22266464
- Inhibitor of kappaB kinase epsilon (IKK(epsilon)), STAT1, and IFIT2 proteins define novel innate immune effector pathway against West Nile virus infection. PMID: 22065572
顯示更多
收起更多
-
亞細胞定位:Cytoplasm. Nucleus. Nucleus, PML body.
-
蛋白家族:Protein kinase superfamily, Ser/Thr protein kinase family, I-kappa-B kinase subfamily
-
組織特異性:Highly expressed in spleen followed by thymus, peripheral blood leukocytes, pancreas, placenta. Weakly expressed in lung, kidney, prostate, ovary and colon.
-
數據庫鏈接:
Most popular with customers
-
-
YWHAB Recombinant Monoclonal Antibody
Applications: ELISA, WB, IHC, IF, FC
Species Reactivity: Human, Mouse, Rat
-
Phospho-YAP1 (S127) Recombinant Monoclonal Antibody
Applications: ELISA, WB, IHC
Species Reactivity: Human
-
-
-
-
-